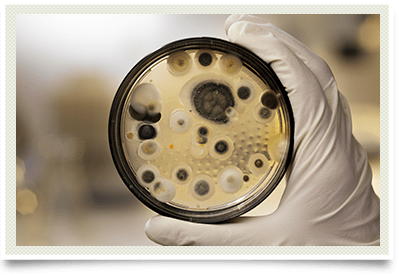

Molds and Mycotoxins
Chemical Toxins
Mold is a fungal growth present all over the earth. It is found both indoors and outdoors in all seasons and climates. It requires moisture and a carbon source for nutrition. Certain species of molds produce chemical toxins called mycotoxins. Mycotoxins are monitored in the food supply by the United States Department of Agriculture as they are known to cause significant health problems in humans and livestock. Aflatoxin, a mycotoxin produced by aspergillus mold, has been associated with liver cancer for decades. Current medical literature has implicated mycotoxins in a large number of health symptoms.
Mycotoxins can be documented in the human body using a provoked urinalysis. The cost of the urinalysis is usually not covered by any third party payers. There are treatment protocols available for mycotoxin removal from the body. These protocols are not approved by the FDA and there is not an FDA approved pharmaceutical product for removal of mycotoxins. A follow-up urinalysis is performed annually to document removal of the mycotoxins from the patient's body. It is critical for the affected patient to remediate or remove themselves from the moldy environment in order for the treatment protocol to be successful.
Protocols and Intravenous Therapies
Due to genetic variations in patients, other xenobiotics such as hydrocarbon based chemicals and heavy metals are found in environmentally ill patients' systems. There are other non-FDA approved protocols and intravenous therapies available for management of these xenobiotics. The foundation of environmental medicine practice is to reduce the total body load of xenobiotics in environmentally ill patients to improve their health. Due to the sequestration of xenobiotics in the patients' systems, this is usually a multi-year exercise performed as an outpatient as hospitalization is never needed for these chronic medical conditions.
» Read more on Mold Allergies
» Read more on Inhalant Allergies: Mycotoxins
